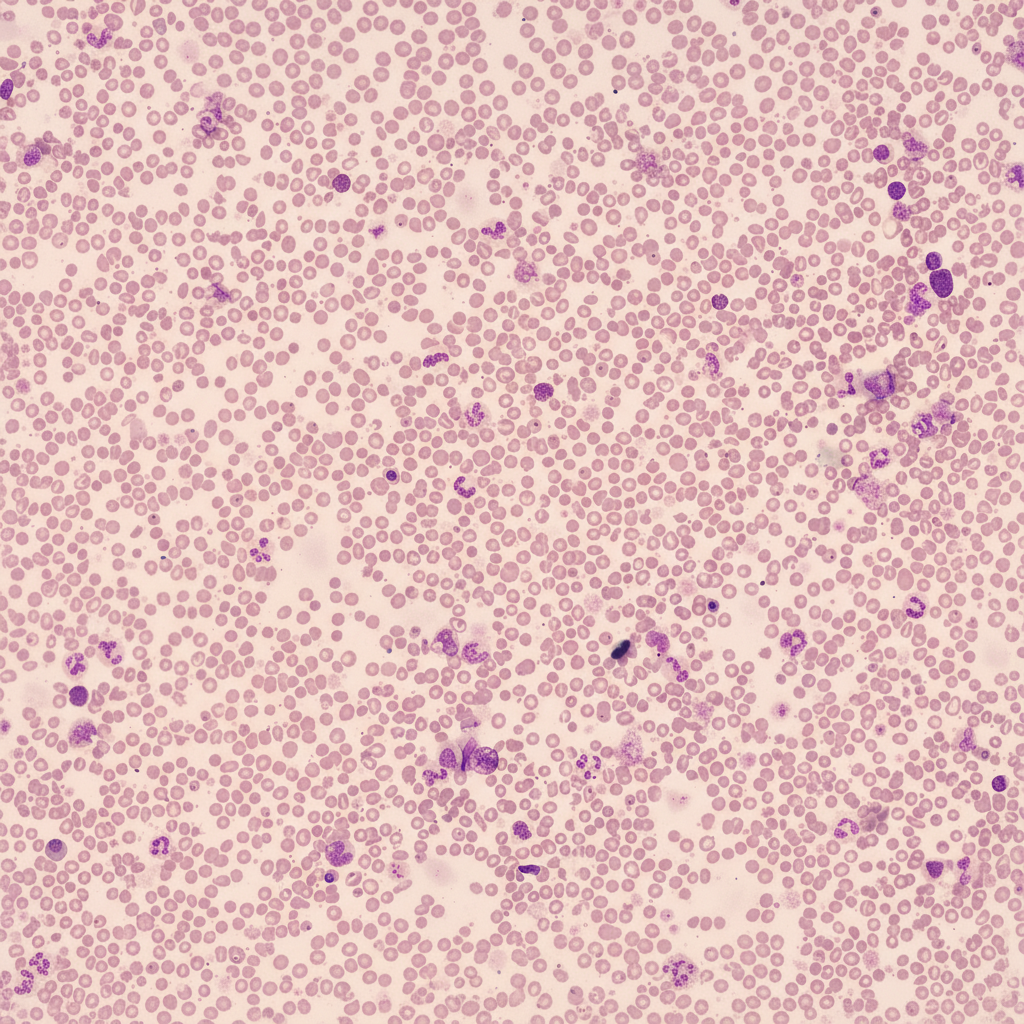
Image for question 349

What is true about Chediak Higashi syndrome?
Molecular studies on an abdominal lymph node containing lymphoma demonstrate t(2;8)(p12;q24) translocation. This is most compatible with which of the following diseases?
Which of the following proteins are involved in Hereditary spherocytosis?
Subnormal serum ferritin is seen in all of the following conditions except:
The Myd88 L265P mutation is characteristically seen in which of the following conditions?
What is the most common cause of aplastic anemia?
Mantle cell lymphomas are positive for all of the following markers except?
TRAP positivity is seen with which of the following hematologic malignancies?
A 30-year-old female with anemia, unresponsive to iron, folic acid, and B12 supplementation, underwent further evaluation. Her CBC profile showed Hb-4.7 g/dL, total WBC count-4,000/mm3, and platelet count-70,000/mm3. Peripheral smear findings are provided. Her bone marrow aspirate revealed a dry tap, and a bone marrow biopsy confirmed the diagnosis. Which of the following stains would have been useful in confirming the bone marrow biopsy findings?
An elderly male presents with headache, recurrent infections, and multiple punched-out lytic lesions on X-ray skull. Which of the following investigations will best help in establishing the diagnosis?
Explanation: **Explanation:** **Chediak-Higashi Syndrome (CHS)** is a rare, autosomal recessive immunodeficiency disorder characterized by a defect in the **LYST gene** (Lysosomal Trafficking Regulator). This defect leads to impaired vesicle fusion and the formation of pathognomonic **giant lysosomal granules** in neutrophils and other cells [1]. 1. **Why "Impaired Bacteriolysis" is correct:** In CHS, although neutrophils can phagocytose bacteria, the fusion of phagosomes with the giant lysosomes is defective [1]. This prevents the delivery of lytic enzymes and reactive oxygen species to the phagosome, resulting in a failure to kill ingested bacteria (impaired bacteriolysis). This leads to recurrent pyogenic infections [1]. 2. **Why other options are incorrect:** * **A. Neutrophilia:** CHS is actually associated with **neutropenia** [1]. The giant granules cause ineffective hematopoiesis in the bone marrow and increased peripheral destruction of fragile neutrophils. * **C. Autosomal Dominant:** CHS follows an **Autosomal Recessive** inheritance pattern [1]. * **D. Associated with Polycythemia:** There is no association with polycythemia. Patients often present with pancytopenia, especially during the "accelerated phase" (lymphohistiocytic infiltration). **High-Yield Clinical Pearls for NEET-PG:** * **Clinical Tetrad:** Partial oculocutaneous albinism, recurrent pyogenic infections, progressive neurological abnormalities, and bleeding tendencies (due to dense granule deficiency in platelets) [1]. * **Peripheral Smear:** Look for **massive/giant azurophilic granules** in the cytoplasm of neutrophils and precursors [1]. * **Accelerated Phase:** A life-threatening, lymphoma-like syndrome characterized by hepatosplenomegaly and lymphadenopathy. **References:** [1] Kumar V, Abbas AK, et al.. Robbins and Cotran Pathologic Basis of Disease. 9th ed. Diseases of the Immune System, pp. 245-246.
Explanation: **Explanation:** The correct answer is **Burkitt's lymphoma**. **1. Why Burkitt's lymphoma is correct:** Burkitt's lymphoma is characterized by the translocation of the **c-MYC proto-oncogene** (located on chromosome **8q24**) to one of the immunoglobulin (Ig) gene loci [1]. The most common translocation is **t(8;14)** (80% of cases), involving the Ig heavy chain [1]. However, variant translocations occur in 20% of cases: * **t(2;8)(p12;q24):** c-MYC moves to the **kappa (κ) light chain** locus on chromosome 2. * **t(8;22)(q24;q11):** c-MYC moves to the **lambda (λ) light chain** locus on chromosome 22. In all these variants, the overexpression of c-MYC drives rapid cellular proliferation [1]. **2. Why the other options are incorrect:** * **Mantle cell lymphoma:** Characterized by **t(11;14)**, leading to overexpression of **Cyclin D1** (PRAD1 gene) [2]. * **Multiple myeloma:** Often associated with various translocations involving the IgH locus (14q32), most commonly **t(11;14)** or **t(4;14)**, but not specifically defined by t(2;8). * **Small lymphocytic lymphoma (SLL):** Typically lacks specific diagnostic translocations; it is often associated with deletions (e.g., 13q, 11q, 17p) or trisomy 12 [2]. **3. High-Yield Clinical Pearls for NEET-PG:** * **Morphology:** "Starry-sky" appearance (tingible body macrophages against a background of neoplastic B-cells). * **Immunophenotype:** CD19+, CD20+, CD10+, BCL6+, but **BCL2 negative**. * **Proliferation Index:** Ki-67 index is typically nearly **100%**. * **Associations:** Strongly linked to **Epstein-Barr Virus (EBV)**, especially the endemic (African) jaw-swelling variant. **References:** [1] Kumar V, Abbas AK, et al.. Robbins and Cotran Pathologic Basis of Disease. 9th ed. Neoplasia, pp. 324-325. [2] Kumar V, Abbas AK, et al.. Robbins and Cotran Pathologic Basis of Disease. 9th ed. Diseases of White Blood Cells, Lymph Nodes, Spleen, and Thymus, pp. 610-612.
Explanation: **Explanation:** Hereditary Spherocytosis (HS) is an autosomal dominant (most common) or recessive disorder characterized by defects in the red blood cell (RBC) membrane skeleton [1]. The primary pathology involves a deficiency or dysfunction of proteins that tether the lipid bilayer to the underlying cytoskeleton. **Why Option B is Correct:** The RBC membrane stability depends on vertical interactions between the lipid bilayer and the cytoskeleton. The key proteins involved in these interactions are **Ankyrin** (the most common deficiency in HS), **Spectrin** (alpha and beta chains), **Band 3**, **Protein 4.2**, and **Rh-associated glycoprotein** [1]. While "Pyrin" is traditionally associated with Familial Mediterranean Fever, in the context of this specific question's options, it refers to the structural components or associated proteins within the vertical complex. (Note: In standard textbooks like Robbins, the primary triad is Ankyrin, Spectrin, and Band 3/4.2) [1]. **Analysis of Incorrect Options:** * **Option A:** While Spectrin, Ankyrin, and Band 4.2 are all involved, this option is less "complete" in the context of typical four-choice MCQ structures where a specific triad is tested. * **Option C:** **Actin** is involved in horizontal interactions (forming the junctional complex with Protein 4.1). Defects in horizontal interactions typically lead to **Hereditary Elliptocytosis**, not Spherocytosis [1]. * **Option D:** This is incomplete as it omits other crucial stabilizing proteins like Band 3 or Protein 4.2. **NEET-PG High-Yield Pearls:** * **Most Common Molecular Defect:** Ankyrin deficiency. * **Pathophysiology:** Loss of membrane surface area leads to a decrease in the surface-to-volume ratio, resulting in a spherical shape [1]. These cells are sequestered and destroyed in the **splenic sinusoids** [1]. * **Diagnosis:** Increased **MCHC** (highly characteristic), increased osmotic fragility, and a positive **EMA Binding test** (Flow cytometry - Gold Standard). * **Peripheral Smear:** Spherocytes (small, dark RBCs lacking central pallor) and polychromasia (reticulocytosis). **References:** [1] Kumar V, Abbas AK, et al.. Robbins and Cotran Pathologic Basis of Disease. 9th ed. Red Blood Cell and Bleeding Disorders, pp. 640-641.
Explanation: **Explanation:** Serum ferritin is the most sensitive and specific indicator of total body iron stores. The question asks for the condition where ferritin is **not** subnormal (i.e., it is normal or elevated). **1. Why Anemia of Chronic Disease (ACD) is the Correct Answer:** In ACD, the primary pathology is the sequestration of iron within macrophages due to high levels of **Hepcidin** (an acute-phase reactant) [1]. While serum iron is low, the **ferritin levels are typically normal or elevated** because ferritin itself acts as a positive acute-phase reactant [1]. The body has iron, but it is "locked away" and unavailable for erythropoiesis [1]. **2. Analysis of Incorrect Options:** * **Iron Deficiency Anemia (IDA):** This is the classic cause of subnormal ferritin [2]. A low serum ferritin (<15–30 ng/mL) is diagnostic of depleted iron stores. * **Liver Disease:** While acute liver injury can cause a "false" rise in ferritin (due to hepatocyte release), chronic liver disease or malnutrition associated with it can lead to genuinely low iron stores and subnormal ferritin. * **Hypothyroidism:** Thyroid hormones are essential for the synthesis of ferritin. Hypothyroidism can lead to decreased ferritin production and is frequently associated with iron deficiency due to impaired absorption (achlorhydria). **NEET-PG High-Yield Pearls:** * **Best screening test for IDA:** Serum Ferritin (it is the first parameter to decrease). * **Gold Standard for iron stores:** Bone marrow aspiration (Prussian blue staining). * **ACD vs. IDA:** In ACD, Ferritin is ↑ and TIBC is ↓. In IDA, Ferritin is ↓ and TIBC is ↑ [1]. * **Soluble Transferrin Receptor (sTfR) index:** Used to differentiate IDA from ACD when ferritin is equivocal (sTfR is elevated in IDA but normal in ACD). **References:** [1] Kumar V, Abbas AK, et al.. Robbins and Cotran Pathologic Basis of Disease. 9th ed. Red Blood Cell and Bleeding Disorders, pp. 660-662. [2] Kumar V, Abbas AK, et al.. Robbins and Cotran Pathologic Basis of Disease. 9th ed. Red Blood Cell and Bleeding Disorders, pp. 659-660.
Explanation: **Explanation:** The **MYD88 L265P mutation** is a landmark genetic discovery in hematopathology, found in over **90–95% of cases of Waldenström Macroglobulinemia (WM)**. 1. **Why Waldenström Macroglobulinemia is Correct:** WM is a lymphoplasmacytic lymphoma (LPL) characterized by bone marrow infiltration and a monoclonal IgM spike [2], [3]. The MYD88 L265P mutation leads to a gain-of-function where the MYD88 protein (an adaptor protein in Toll-like receptor signaling) is constitutively active. This triggers the **NF-κB pathway**, promoting the survival and proliferation of malignant B-cells. Its high prevalence makes it a crucial diagnostic marker to differentiate WM from other B-cell malignancies. 2. **Why Other Options are Incorrect:** * **Multiple Myeloma:** While it involves plasma cells and monoclonal spikes (usually IgG or IgA), it is characterized by complex cytogenetics (e.g., t(11;14), del 17p) rather than the MYD88 mutation [1], [3]. * **Acute Lymphoblastic Leukemia (ALL):** ALL is driven by chromosomal translocations like t(12;21) or t(9;22) and Notch1 mutations (in T-ALL), not MYD88. * **Chronic Myeloid Leukemia (CML):** The hallmark of CML is the **Philadelphia chromosome [t(9;22)]** resulting in the BCR-ABL1 fusion gene. **High-Yield Clinical Pearls for NEET-PG:** * **CXCR4 mutations:** Seen in ~30-40% of WM cases; they often correlate with resistance to ibrutinib (a BTK inhibitor). * **Hyperviscosity Syndrome:** A classic presentation of WM due to large IgM pentamers [1], [2]. * **Differential Diagnosis:** If a patient has an IgM spike but **no** MYD88 mutation, consider other LPLs or Marginal Zone Lymphoma. **References:** [1] Kumar V, Abbas AK, et al.. Robbins and Cotran Pathologic Basis of Disease. 9th ed. Diseases of White Blood Cells, Lymph Nodes, Spleen, and Thymus, pp. 608-609. [2] Kumar V, Abbas AK, et al.. Robbins and Cotran Pathologic Basis of Disease. 9th ed. Diseases of White Blood Cells, Lymph Nodes, Spleen, and Thymus, pp. 609-610. [3] Cross SS. Underwood's Pathology: A Clinical Approach. 6th ed. Common Clinical Problems From Blood And Bone Marrow Disease, pp. 616-617.
Explanation: **Explanation:** Aplastic anemia is a bone marrow failure syndrome characterized by pancytopenia and a hypocellular bone marrow [1]. **Why "Exposure to drugs" is correct:** Acquired aplastic anemia is far more common than inherited forms. Among acquired causes, **drugs and chemicals** are the most frequent triggers [1]. These can cause marrow suppression via two mechanisms: 1. **Dose-dependent (Predictable):** e.g., Cytotoxic chemotherapy agents (Busulfan, Methotrexate) [1]. 2. **Idiosyncratic (Unpredictable):** e.g., Chloramphenicol (classic association), NSAIDs (Phenylbutazone), and Anticonvulsants (Phenytoin) [1]. While most cases are technically "idiopathic" (where no cause is found) [1], among the identifiable triggers, drugs remain the leading category. **Why other options are incorrect:** * **Viral hepatitis:** While "Hepatitis-associated aplasia" is a recognized entity (usually occurring 2–3 months after an episode of non-A, non-B, non-C hepatitis), it accounts for only 5–10% of cases [1]. * **Fanconi anemia:** This is the most common *inherited* cause of aplastic anemia, but it is rare compared to the acquired forms seen in clinical practice [1]. * **Fungal infection:** Infections like Parvovirus B19 can cause transient aplastic crises (especially in hemolytic anemia patients), but fungal infections are not a primary cause of aplastic anemia [1]. **High-Yield NEET-PG Pearls:** * **Gold Standard Diagnosis:** Bone marrow biopsy showing "dry tap" and replacement of hematopoietic elements by **fat cells** [2]. * **Most common drug associated:** Chloramphenicol (historically) and Phenylbutazone [1]. * **Treatment of choice:** Bone marrow transplantation (in young patients) or Immunosuppressive therapy (Antithymocyte globulin + Cyclosporine) [2]. * **PNH Connection:** Aplastic anemia can evolve into Paroxysmal Nocturnal Hemoglobinuria (PNH) or Myelodysplastic Syndrome (MDS) [1]. **References:** [1] Cross SS. Underwood's Pathology: A Clinical Approach. 6th ed. Common Clinical Problems From Blood And Bone Marrow Disease, pp. 595-596. [2] Kumar V, Abbas AK, et al.. Robbins and Cotran Pathologic Basis of Disease. 9th ed. Red Blood Cell and Bleeding Disorders, pp. 662-663.
Explanation: **Explanation:** Mantle Cell Lymphoma (MCL) is a B-cell neoplasm typically characterized by the translocation **t(11;14)**, which leads to the overexpression of **Cyclin D1** [1]. Understanding its immunophenotype is crucial for differentiating it from other small B-cell lymphomas, particularly Chronic Lymphocytic Leukemia (CLL/SLL). **1. Why CD23 is the correct answer:** Mantle cell lymphoma is characteristically **CD23 negative**. CD23 is a key marker used to differentiate MCL from CLL/SLL (which is CD23 positive). In the "Small B-cell Lymphoma" differential, MCL is typically CD5+, CD20+, and Cyclin D1+, but lacks CD23 and CD10 [1]. **2. Analysis of Incorrect Options:** * **CD20:** This is a pan-B-cell marker. Since MCL is a B-cell lymphoma, it expresses CD20 strongly [1]. * **CD5:** MCL is one of the two major B-cell lymphomas that are **CD5 positive** (the other being CLL/SLL). This marker helps narrow the diagnosis to these two entities. * **Cyclin D1:** This is the hallmark of MCL [1]. The t(11;14) translocation brings the *CCND1* gene under the influence of the IgH promoter, leading to constitutive expression of Cyclin D1, which promotes cell cycle progression. **High-Yield Clinical Pearls for NEET-PG:** * **Genetics:** t(11;14) involving *BCL-1* (Cyclin D1) and *IgH*. * **Morphology:** Look for "centrocyte-like" cells and a "hyalinized arteriole" in the lymph node [1]. * **Clinical Presentation:** Often presents at an advanced stage; may show **Lymphomatous Polyposis** (multiple nodules in the GI tract). * **SOX11:** A highly specific nuclear marker for MCL, especially useful in Cyclin D1-negative cases. * **Aggressive Variant:** The **Blastoid variant** has a very high mitotic rate and poor prognosis [1]. **References:** [1] Kumar V, Abbas AK, et al.. Robbins and Cotran Pathologic Basis of Disease. 9th ed. Diseases of White Blood Cells, Lymph Nodes, Spleen, and Thymus, pp. 610-612.
Explanation: **Explanation:** **Hairy Cell Leukemia (HCL)** is the correct answer because it is the classic hematologic malignancy associated with **TRAP (Tartrate-Resistant Acid Phosphatase)** positivity. TRAP is an isoenzyme (Isoenzyme 5) of acid phosphatase. While most cells contain acid phosphatase that is inhibited by tartrate, the leukemic cells in HCL contain an abundance of this specific isoenzyme that remains active despite the addition of tartrate, leading to a positive cytochemical stain. **Analysis of Options:** * **Chronic Myeloid Leukemia (CML):** Characterized by a **low Leukocyte Alkaline Phosphatase (LAP)** score (also known as Neutrophil Alkaline Phosphatase/NAP). TRAP is not used for its diagnosis. * **Chronic Lymphocytic Leukemia (CLL):** A mature B-cell neoplasm characterized by "smudge cells" and specific markers like CD5 and CD23 [2]. It is TRAP-negative. * **Follicular Lymphoma:** A germinal center B-cell lymphoma characterized by the t(14;18) translocation and BCL-2 expression [3]. It does not show TRAP positivity. **High-Yield Clinical Pearls for NEET-PG:** * **Morphology:** HCL cells show characteristic "hair-like" cytoplasmic projections [1]. * **Clinical Triad:** Splenomegaly (often massive), Pancytopenia, and **Dry Tap** on bone marrow aspiration (due to increased reticulin fibrosis) [1]. * **Immunophenotype:** Positive for CD11c, CD25, CD103 (most specific), and Annexin A1. * **Genetic Mutation:** Virtually all cases harbor the **BRAF V600E** mutation. * **Treatment:** Highly sensitive to Purine analogs like **Cladribine** (2-CdA) or Pentostatin. **References:** [1] Kumar V, Abbas AK, et al.. Robbins and Cotran Pathologic Basis of Disease. 9th ed. Diseases of White Blood Cells, Lymph Nodes, Spleen, and Thymus, p. 612. [2] Kumar V, Abbas AK, et al.. Robbins and Cotran Pathologic Basis of Disease. 9th ed. Diseases of White Blood Cells, Lymph Nodes, Spleen, and Thymus, p. 602. [3] Kumar V, Abbas AK, et al.. Robbins and Cotran Pathologic Basis of Disease. 9th ed. Diseases of White Blood Cells, Lymph Nodes, Spleen, and Thymus, pp. 602-604.
Explanation: ***Reticulin stain*** - **Reticulin stain** is the **gold standard** for demonstrating increased **reticulin fibers** in bone marrow, confirming **myelofibrosis** diagnosis. - The **WHO grading system** (MF-0 to MF-3) uses reticulin stain to assess **fibrosis severity** and guide treatment decisions. *Myeloperoxidase (MPO)* - **MPO stain** is used to identify **myeloid lineage cells** and differentiate **acute myeloid leukemia** from other hematologic malignancies. - Not useful for detecting **bone marrow fibrosis** or **reticulin fiber deposition** in myelofibrotic disorders. *Verhoeff-Van Gieson (VVG)* - **VVG stain** demonstrates **elastic fibers** and is primarily used in **cardiovascular pathology** and **connective tissue disorders**. - Does not specifically highlight **reticulin fibers** needed for diagnosing **bone marrow fibrosis**. *Prussian blue stain (for iron)* - **Prussian blue stain** detects **iron deposits** in tissues and is useful for diagnosing **iron overload** or **sideroblastic anemia**. - Cannot demonstrate **reticulin fibrosis** or help confirm **myelofibrosis** in bone marrow specimens.
Explanation: **Explanation:** The clinical presentation of an elderly male with headache, recurrent infections, and **punched-out lytic lesions** on the skull is classic for **Multiple Myeloma (MM)** [1]. **Why Protein Electrophoresis is the correct answer:** Multiple Myeloma is a plasma cell dyscrasia characterized by the monoclonal proliferation of plasma cells in the bone marrow [2]. These cells produce excessive amounts of a single type of immunoglobulin (M-protein) [1]. **Serum Protein Electrophoresis (SPEP)** is the gold standard screening investigation as it identifies the characteristic **"M-spike"** (usually in the gamma or beta region), which confirms the presence of monoclonal gammopathy and establishes the diagnosis [4]. **Analysis of Incorrect Options:** * **A. Serum Calcium:** While hypercalcemia is a common feature of MM (part of the CRAB criteria), it is non-specific and occurs in many other malignancies and metabolic disorders [1]. It does not confirm the diagnosis. * **C. Acid Phosphatase:** This is a marker historically used for prostate cancer (Prostatic Acid Phosphatase) or Gaucher’s disease. It has no diagnostic value in MM. * **D. Alkaline Phosphatase (ALP):** In MM, the bone lesions are purely lytic (osteoclast-driven) without osteoblastic activity. Therefore, **ALP levels are typically normal**, which helps differentiate MM from other bone pathologies like Paget’s disease or osteoblastic metastases. **Clinical Pearls for NEET-PG:** * **CRAB Criteria:** **C**alcium elevation, **R**enal insufficiency, **A**nemia, **B**one lesions [1]. * **Peripheral Smear:** Shows **Rouleaux formation** due to increased globulins [3]. * **Urine:** May show **Bence-Jones proteins** (detected by Sulfosalicylic acid test or Urine Electrophoresis, not by routine dipstick) [3]. * **Bone Marrow:** Definitive diagnosis requires >10% clonal plasma cells. Look for "Flame cells" or "Mott cells." **References:** [1] Kumar V, Abbas AK, et al.. Robbins and Cotran Pathologic Basis of Disease. 9th ed. Diseases of White Blood Cells, Lymph Nodes, Spleen, and Thymus, p. 608. [2] Cross SS. Underwood's Pathology: A Clinical Approach. 6th ed. Common Clinical Problems From Blood And Bone Marrow Disease, pp. 616-617. [3] Kumar V, Abbas AK, et al.. Robbins and Cotran Pathologic Basis of Disease. 9th ed. Diseases of White Blood Cells, Lymph Nodes, Spleen, and Thymus, pp. 607-608. [4] Kumar V, Abbas AK, et al.. Robbins and Cotran Pathologic Basis of Disease. 9th ed. Diseases of White Blood Cells, Lymph Nodes, Spleen, and Thymus, pp. 608-609.
Anemias: Classification and Approach
Practice Questions
Hemolytic Anemias
Practice Questions
Myeloproliferative Neoplasms
Practice Questions
Myelodysplastic Syndromes
Practice Questions
Acute Leukemias
Practice Questions
Chronic Leukemias
Practice Questions
Lymphomas and Lymphoid Neoplasms
Practice Questions
Plasma Cell Disorders
Practice Questions
Bleeding Disorders
Practice Questions
Thrombotic Disorders
Practice Questions
Get full access to all questions, explanations, and performance tracking.
Start For Free